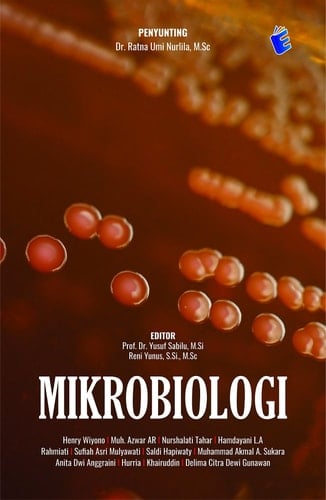
Mikrobiologi

Selamat datang dalam dunia kecil yang tak terlihat, tetapi memiliki dampak besar pada kehidupan kita. Buku ini, "Mikrobiologi: Memahami Kehidupan di Balik Mikroskop," adalah panduan komprehensif yang menggali ke dalam makhluk-makhluk kecil yang menghuni dunia mikroba. Mikroorganisme, yang terdiri dari bakteri, virus, jamur, dan protozoa, telah ada sejak awal kehidupan di Bumi. Mereka mendiami setiap sudut planet ini, dari dasar lautan hingga ke dalam tanah yang paling dalam. Mikrobiologi adalah kunci untuk memahami peran kritis yang dimainkan oleh mikroorganisme ini dalam siklus kehidupan, kesehatan manusia, dan ekosistem kita. Dalam buku ini, menguraikan berbagai aspek mikrobiologi, mulai dari dasar-dasar struktur sel mikroba hingga aplikasi praktisnya dalam industri, kedokteran, dan lingkungan. Anda akan menemukan bagaimana mikroorganisme berperan dalam pembuatan makanan, pengobatan penyakit, dan bahkan menjaga keseimbangan ekosistem Bumi. Pengetahuan yang Anda peroleh dari buku ini akan membantu Anda menghargai pentingnya mikrobiologi dalam kehidupan sehari-hari kita. Kami berharap buku ini akan memotivasi Anda untuk menjelajahi lebih lanjut dunia mikroba, menggali pengetahuan baru, dan mungkin bahkan mengambil bagian dalam riset yang akan membentuk masa depan mikrobiologi. Buku Mikrobiologi yang berada ditangan pembaca ini terdiri atas 12 bab, yaitu: BAB 1 Pengertian Dan Konsep Dasar Mikrobiologi BAB 2 Sejarah Perkembangan Mikrobiologi Sebagai Suatu Ilmu BAB 3 Keanekaragaman Mikrobia BAB 4 Metoda Dan Teknik Pengenalan BAB 5 Pengukuran Pertumbuhan Mikrobia BAB 6 Mengidentifikasi Mikrobia BAB 7 Nutrisi Dan Metabolisme Pada Mikrobia BAB 8 Pertumbuhan Dan Faktor Yang Mempengaruhi Pertumbuhan Mikrobia BAB 9 Aspek Molekular Di Dalam Kestabilan Sifat Mikrobia Yang Berkaitan Dengan DNA Sebagai Penyimpan Informasi Genetik BAB 10 Peran Mikrobia Di Bidang Kesehatan BAB
Page Count:
208
Publication Date:
2023-10-14
ISBN-10:
623151658X
ISBN-13:
9786231516589
No comments yet. Be the first to share your thoughts!